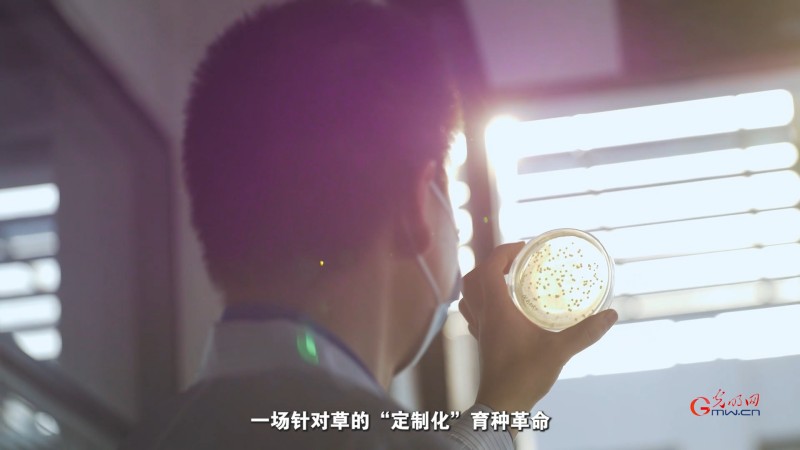
生态、生产、生活同频共振：科技如何让草原既绿又富？

点击右上角
微信好友
朋友圈

请使用浏览器分享功能进行分享

草不仅是草原的底色,更是生态与产业的纽带。如何让草业既扎根大地,又拥抱科技?中国科学院院士、中国植物学会理事长种康在接受光明网记者专访时表示,草作为生态系统的重要组成部分,其研究与发展不仅关乎草原生态保护,更与畜牧业生产、牧民生活改善息息相关。在科技快速发展的今天,通过系统性研究草的生物学特性、推动草种驯化与育种创新、平衡生态保护与产业发展,才能真正实现生态、生产、生活的“三生融合”。

草业研究需走“定制化”道路
“对于草来说,它有一些特性和作物不一样。比如草的育种目标是生物量大,但对作物来讲,比如水稻、小麦等希望籽粒产量更高。”种康表示,尽管育种目标不同,但植物分子生物学的前沿理论探索,仍能为饲草作物的开发利用提供重要理论基础。
在种康看来,我国草学研究在基础理论和应用技术上,整体要落后于作物研究。“草的基本生物学特性和作物存在显著差异,而且关于草的基础生物学知识,比水稻等作物少得多。”他坦言,这种滞后性正是中国科学院战略性先导科技专项关注草业发展的重要原因——“我们希望草品种培育与草业发展能跟上现代生物学的前沿,实现跨越式进步,但这绝不是简单移植作物研究的成果。”植物科学的基础研究成果是共通的,无论是作物还是草,其生长发育、环境响应等基本规律都能从分子生物学中找到理论支撑,关键在于如何对草的饲用性状进行设计、驯化和改良而转化应用。
只有夯实基础研究,才能推动草的育种从传统模式迈向分子育种。“传统育种依赖经验积累,而分子育种能精准靶向性状改良,这需要对草的生物学规律有深刻理解。我们的基础科学研究的目标是为草业育种提供理论支撑,实现从‘跟着走’到‘自主创新’的跨越。”
羊草驯化:从野生到作物的“中国突破”
在草种驯化与育种实践中,羊草的研究是我国草学领域的突出成果。种康介绍,“羊草是欧亚大陆草原中优质的禾本科草,野生羊草在自然状态下生长,但要让它成为可规模化种植的‘作物’,必须经过驯化。”
驯化的核心是改良野生性状以适应农业生产。种康以落粒性和成熟一致性为例,野生羊草种子成熟后会立即脱落,无法大规模收获,这是第一个需要驯化的性状。“我们希望通过改良,让种子成熟后不易脱落,或成熟过程同步性更好,便于集中收获。”
据了解,中国科学院植物研究所刘公社团队从20世纪90年代便投身羊草驯化研究,如今已培育出七八个羊草品种。“从羊草品种培育来看,我们在国际上是独一份的。”种康自豪地说,这些品种主要有两大用途,一是用于退化草原的补播,助力生态修复;二是在特定区域规模化种植,将羊草作为“作物”生产,践行“以小保大”理念。

多方探索实现“三生融合”,平衡生态、生产与生活
“‘以小保大’就是用小面积高产优质草地生产足够饲草,保障更大范围草原的休养生息,解决过度放牧问题。”种康解释,既提高了饲草生产效率,又为草原生态保护留出了空间。
“三生融合——让生态、生产、生活协调发展,找到最佳平衡点,是我们的最高目标。”种康认为。而这恰恰需要科技支撑,既要有良好的生态环境,也要有较高的生产能力,更要让农民牧民的生活形成良性发展循环。
在技术应用上,跨学科融合是关键。“我们的先导专项中,就有‘空天地一体化’技术的应用。”种康举例,通过卫星遥感、无人机监测,无需询问牧户,就能精准掌握牲畜数量,计算出草地的承载能力,“这让生态保护与生产规划更精准,避免过度放牧破坏草原。”
此外,利用边际土地和低产的一般耕地发展草业,是兼顾生态与增收的创新路径。“把这些土地用于种草,再通过种草养畜生产肉、乳,既能提高土地利用效率,又能增加牧民收入,这是平衡生态、生产与生活的有效尝试。”
在饲草利用环节,科技同样能提升价值。种康提到,“传统草类利用是初级的,割下来或放牧让牛羊吃,储存过程中营养流失严重。而青贮技术能最大程度保留草的营养,显著提高饲草质量,间接提升畜牧业效益。”
从制草、种草到养畜,每个环节都需要科学支撑。“我们研究栽培技术、改良育种方法、创新利用模式,就是为了系统性解决生态、生产、生活的协调问题。未来,随着草学基础理论研究的深入和育种新技术的不断研发,科技将为草原可持续发展注入更强动力。”他表示。
草业发展是一项系统工程,需要基础研究、技术创新、产业应用协同推进。“让草原更绿、产业更强、牧民更富,这是我们草学研究者的朴素追求,也是科技赋能生态文明建设的生动实践。”(记者武玥彤 李欣哲)
